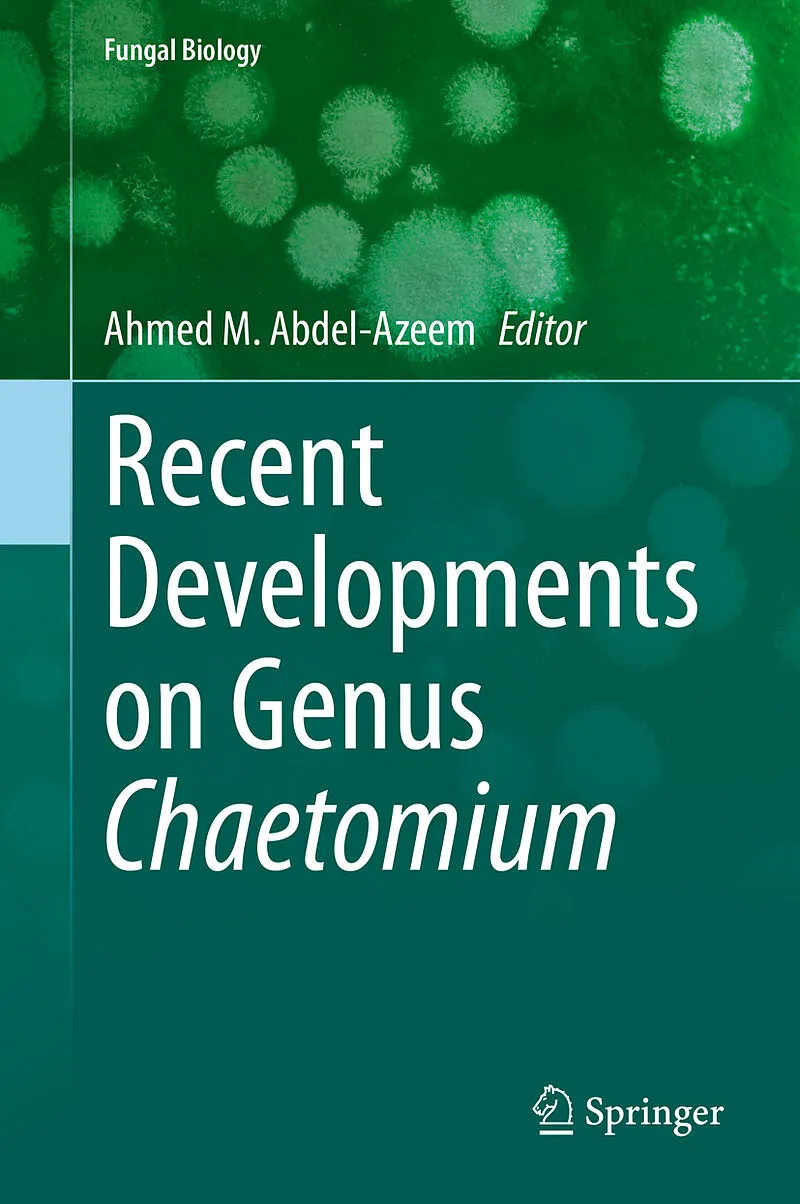

Recent Developments on Genus Chaetomium
Beschreibung
Chaetomium genus was established by Gustav Kunze in 1817. According to Index Fungorum Partnership, there are 273 Chaetomium species accepted till now. Members of the genus Chaetomium are capable of colonizing various substrates and are well-known for their ab...Format auswählen
- Fester EinbandCHF 164.40
- E-Book (pdf)CHF 177.90
- Kartonierter EinbandCHF 180.80
Wird oft zusammen gekauft
Andere Kunden kauften auch
Beschreibung
Chaetomium genus was established by Gustav Kunze in 1817. According to Index Fungorum Partnership, there are 273 Chaetomium species accepted till now. Members of the genus Chaetomium are capable of colonizing various substrates and are well-known for their ability to degrade cellulose and to produce a variety of bioactive metabolites. More than 200 compounds have been reported from this genus. A huge number of new and bioactive secondary metabolites associated with unique and diverse structural types, such as chaetoglobosins, epipolythiodioxopiperazines, azaphilones, depsidones, xanthones, anthraquinones, chromones, and steroids, have been isolated and identified. Many of the compounds have been reported to possess significant biological activities, such as antitumor, antimalarial, cytotoxic, enzyme inhibitory, antimicrobial, phytotoxic, antirheumatoid and other activities. Chaetomium taxa are frequently reported to be cellulase and ligninase producers withthe ability to degrade cellulosic and woody materials.
This is the first, comprehensive volume covering Chaetomium genus in detail. It includes the latest research, methods, and applications, and was written by scholars working directly in the field. The book also contains informative illustrations and is fully referenced for further reading.
Covers the Chaetomium genus in detail Includes the latest research, methods, and applications Written by scholars working directly in the field Contains informative illustrations Fully referenced for further reading
Autorentext
Assistant Prof. Ahmed Abdel-Azeem is currently working as academic staff member for Botany Department, Faculty of Science, Suez Canal University and mycologist with particular interest in the ecology, taxonomy, biology, and conservation of fungi and his specialist interest is members of the phylum Ascomycota. His research includes isolation, identification and taxonomic assessments of these fungi with particular emphasis on those which produce bioactive materials from different ecological habitats. Most recently he has become interested in the effect of climate change on fungi. This in turn has led him to become involved in fungal conservation. He is a member of the IUCN Species Survival Commission Specialist Group for Cup Fungi, Truffles & their Allies, and also the Founder of the Arab Society for Fungal Conservation. In 2014 and 2016 Abdel-Azeem proposed a good candidate for celebration of Egypt's National Fungus Day on the 20th of February. Abdel-Azeem with the help of international societies, agencies and mycologists decreed the Egypt s National Fungus Day in Bibliotheca Alexandrina in the 20th of February 2016 for the first time. He got different grants, fellowships, national and international projects e.g. EOL fellowship in 2011, Mohamed Bin Zayed Species Conservation fund in 2014 and 2018, National Geographic Society Fund in 2016. In 2018 Abdel-Azeem was elected to be a member in the executive Committee of International Mycological Association (IMA) for the next 4 years. He was hired for his experience in taxonomy, ecology, biology, and conservation of fungi to study the fungi in ancient air of unveiled Cheops Solar Boat Project and fungi degraded ancient wood in Abydos Middle Cemetery Project. He studied the biodiversity of macrofungi in Romania, UK, US, Finland, Sweden, Italy, Greece, Puerto Rico and Malta. He is the editor in chief of Microbial Biosystems Journal (MBJ) and a reviewer in more than 7 international journals. Abdel-Azeem published more than 62 research papers journals, 7 book chapters in the books published by international publishers and five books.
Inhalt
Foreword.- Part 1. Chaetomium: Biology to biotechnology.- Chapter 1. Taxonomy and Biodiversity of the Genus Chaetomium in Different Habitats.- Chapter 2. Developmental Morphology of Chaetomium and Chaetomiopsis.- Chapter 3. Molecular approaches for analyzing environmental Chaetomium diversity and exploitation of Chaetomium thermophilum for biochemical analyses.- Chapter 4. Recent advances on occurrence of genus Chaetomium on dung.- Chapter 5. Chaetomium in indoor environment and medically important species of Chaetomium.- Part 2. Metabolites of Chaetomium, the good, the bad and the ugly.- Chapter 6. Recent advancements on the role of biologically active secondary metabolites from Chaetomium.- Chapter 7. Chaetomium's alkaloids.- Chapter 8. Applications of Chaetomium functional metabolites with special reference to antioxidants.- Chapter 9. Chaetomium enzymes and their applications.- Chapter 10. The use of Chaetomium taxa as biocontrol agents.- Chapter 11. Nanoparticles mediated Chaetomium, unique multifunctional Bullets: What Do We Need for Real Applications in Agriculture?.- Chapter 12. Biodegradation of agricultural wastes by Chaetomium species.- Chapter 13. Bioconversion of lignocellulosic residues into Single-Cell Protein (SCP) by Chaetomium.- Chapter 14. LIGHT, Electromagnetic Spectrum and Photostimulation of Microorganisms with special reference to Chaetomium.- Chapter 15. Chaetomium as potential soft rot degrader of woody and papery cultural heritage.- Chapter 16. Thermophilic Chaetomium in biotechnology.- Index.
